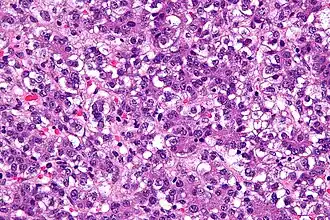
Description de cette image, également commentée ci-après

Hépatoblastome
| Médicament | Cisplatine et doxorubicine |
|---|---|
| Spécialité | Oncologie |
| CIM-10 | C22.0 |
|---|---|
| ICD-O | M8970/3 |
| DiseasesDB | 5799 |
| eMedicine | 986802 |
| MeSH | D018197 |
![]() Mise en garde médicale
Mise en garde médicale
L'hépatoblastome (HB), aussi appelé « tumeur abdominale de l'enfant », est une tumeur maligne rare du foie, de nature hépatocytaire, qui touche les nourrissons et les enfants.
Épidémiologie
L'hépatoblastome est la tumeur hépatique maligne la plus fréquente chez l’enfant[1],[2] de nature hépatocytaire[2]. Elle touche dans la grande majorité des cas l’enfant de moins de 5 ans[1],[2]. Elle reste cependant rare avec une prévalence estimée entre 1 et 9 pour 1 000 000[3].
Le risque de survenue d'un hépatoblastome est très majoré en cas de syndrome de Beckwith-Wiedemann[3],[4],[5] ainsi que de polypose recto-colique familiale[3],[4],[5]. Un poids de naissance inférieur à 1 500 grammes (et donc une prématurité) augmenterait très nettement ce risque[4],[2]. La survenue est plus fréquente chez les sujets de sexe masculin[2]. D'autres facteurs favorisants ont été évoqués : tabagisme parental pendant la grossesse[4] et syndrome d'alcoolisation fœtal[2].
L'incidence de l'hépatoblastome est croissante ces dernières années[5]. Il est avancé que cette augmentation serait liée à la progression du taux de survie des prématurés, qui sont plus à risque de développer un hépatoblastome[5].
Clinique
Les signes cliniques sont totalement aspécifiques[2]. Le principal point d'appel est la découverte d'une masse abdominale ou d'une distension abdominale[5]. Une altération de l'état général est fréquente avec asthénie et anorexie[5]. Une puberté précoce est parfois observée en rapport avec une sécrétion d'hormone chorionique gonadotrope par la tumeur[5].
Biologie
L'alpha-fœtoprotéine (AFP), élevée dans 90 % des cas[2], est le principal marqueur biologique de l'hépatoblastome, que ce soit pour le diagnostic positif ou pour évaluer la réponse thérapeutique[5]. Une élévation de l'AFP au delà de 500 ng/ml est évocatrice d'hépatoblastome. Cependant le dosage peut être pris en défaut puisque certaines formes histologiques d'hépatoblastome ne s'accompagnent pas d'une élévation de l'AFP[5]. Dans ce cas le dosage a une valeur pronostique, ces formes particulières étant de plus mauvais pronostic[5],[6].
Enfin l'élévation de l'AFP n'est pas spécifique puisque rencontrée dans d'autres néoplasies (hépatocarcinome par exemple).
Imagerie
En échographie, l'hépatoblastome se traduit généralement par une volumineuse masse intra-hépatique[5]. L'imagerie en coupe reste supérieure pour le diagnostic (tomodensitométrie ou imagerie par résonance magnétique).
En IRM l'hépatoblastome apparaît globalement en hyposignal T1 et hypersignal T2[2]. Sa structure est très hétérogène avec de fréquentes zones de remaniements hémorragiques[5],[2]. Le rehaussement est plutôt périphérique[2].
Traitement
La chirurgie, la chimiothérapie néo-adjuvante et la transplantation hépatique sont les principales armes thérapeutiques contre l'hépatoblastome. La présence de métastase au moment du diagnostic est le principal facteur de mauvais pronostic.
Références
- 1 2 Valérie Vilgrain et Denis Régent, Imagerie de l'abdomen, Paris, Médecine sciences publications-[Lavoisier], , 1056 p. (ISBN 978-2-257-20417-2, lire en ligne)
- 1 2 3 4 5 6 7 8 9 10 11 Christophe Aubé, IRM du foie et des voies biliaires, Montpellier, Sauramps médical, , 277 p. (ISBN 978-2-84023-695-5, lire en ligne)
- 1 2 3 « Hépatoblastome », sur Orphanet (consulté le )
- 1 2 3 4 Logan G. Spector et Jill Birch, « The epidemiology of hepatoblastoma », Pediatric Blood & Cancer, vol. 59, no 5, , p. 776–779 (ISSN 1545-5017, PMID 22692949, DOI 10.1002/pbc.24215, lire en ligne, consulté le )
- 1 2 3 4 5 6 7 8 9 10 11 12 Eiso Hiyama, « Pediatric hepatoblastoma: diagnosis and treatment », Translational Pediatrics, vol. 3, no 4, , p. 293–299 (ISSN 2224-4344, PMID 26835349, PMCID PMC4728840, DOI 10.3978/j.issn.2224-4336.2014.09.01, lire en ligne, consulté le )
- ↑ (en) M. De Ioris, L. Brugieres, A. Zimmermann, J. Keeling, P. Brock, R. Maibach, J. Pritchard, L. Shafford, J. Zsiros, P. Czaudzerna et G. Perilongo, « Hepatoblastoma with a low serum alpha-fetoprotein level at diagnosis: The SIOPEL group experience. », Eur J Cancer, vol. 44, no 4, , p. 545–50 (PMID 18166449, DOI 10.1016/j.ejca.2007.11.022)
- Portail de la médecine
- Portail de la biologie cellulaire et moléculaire
- Portail de l'enfance